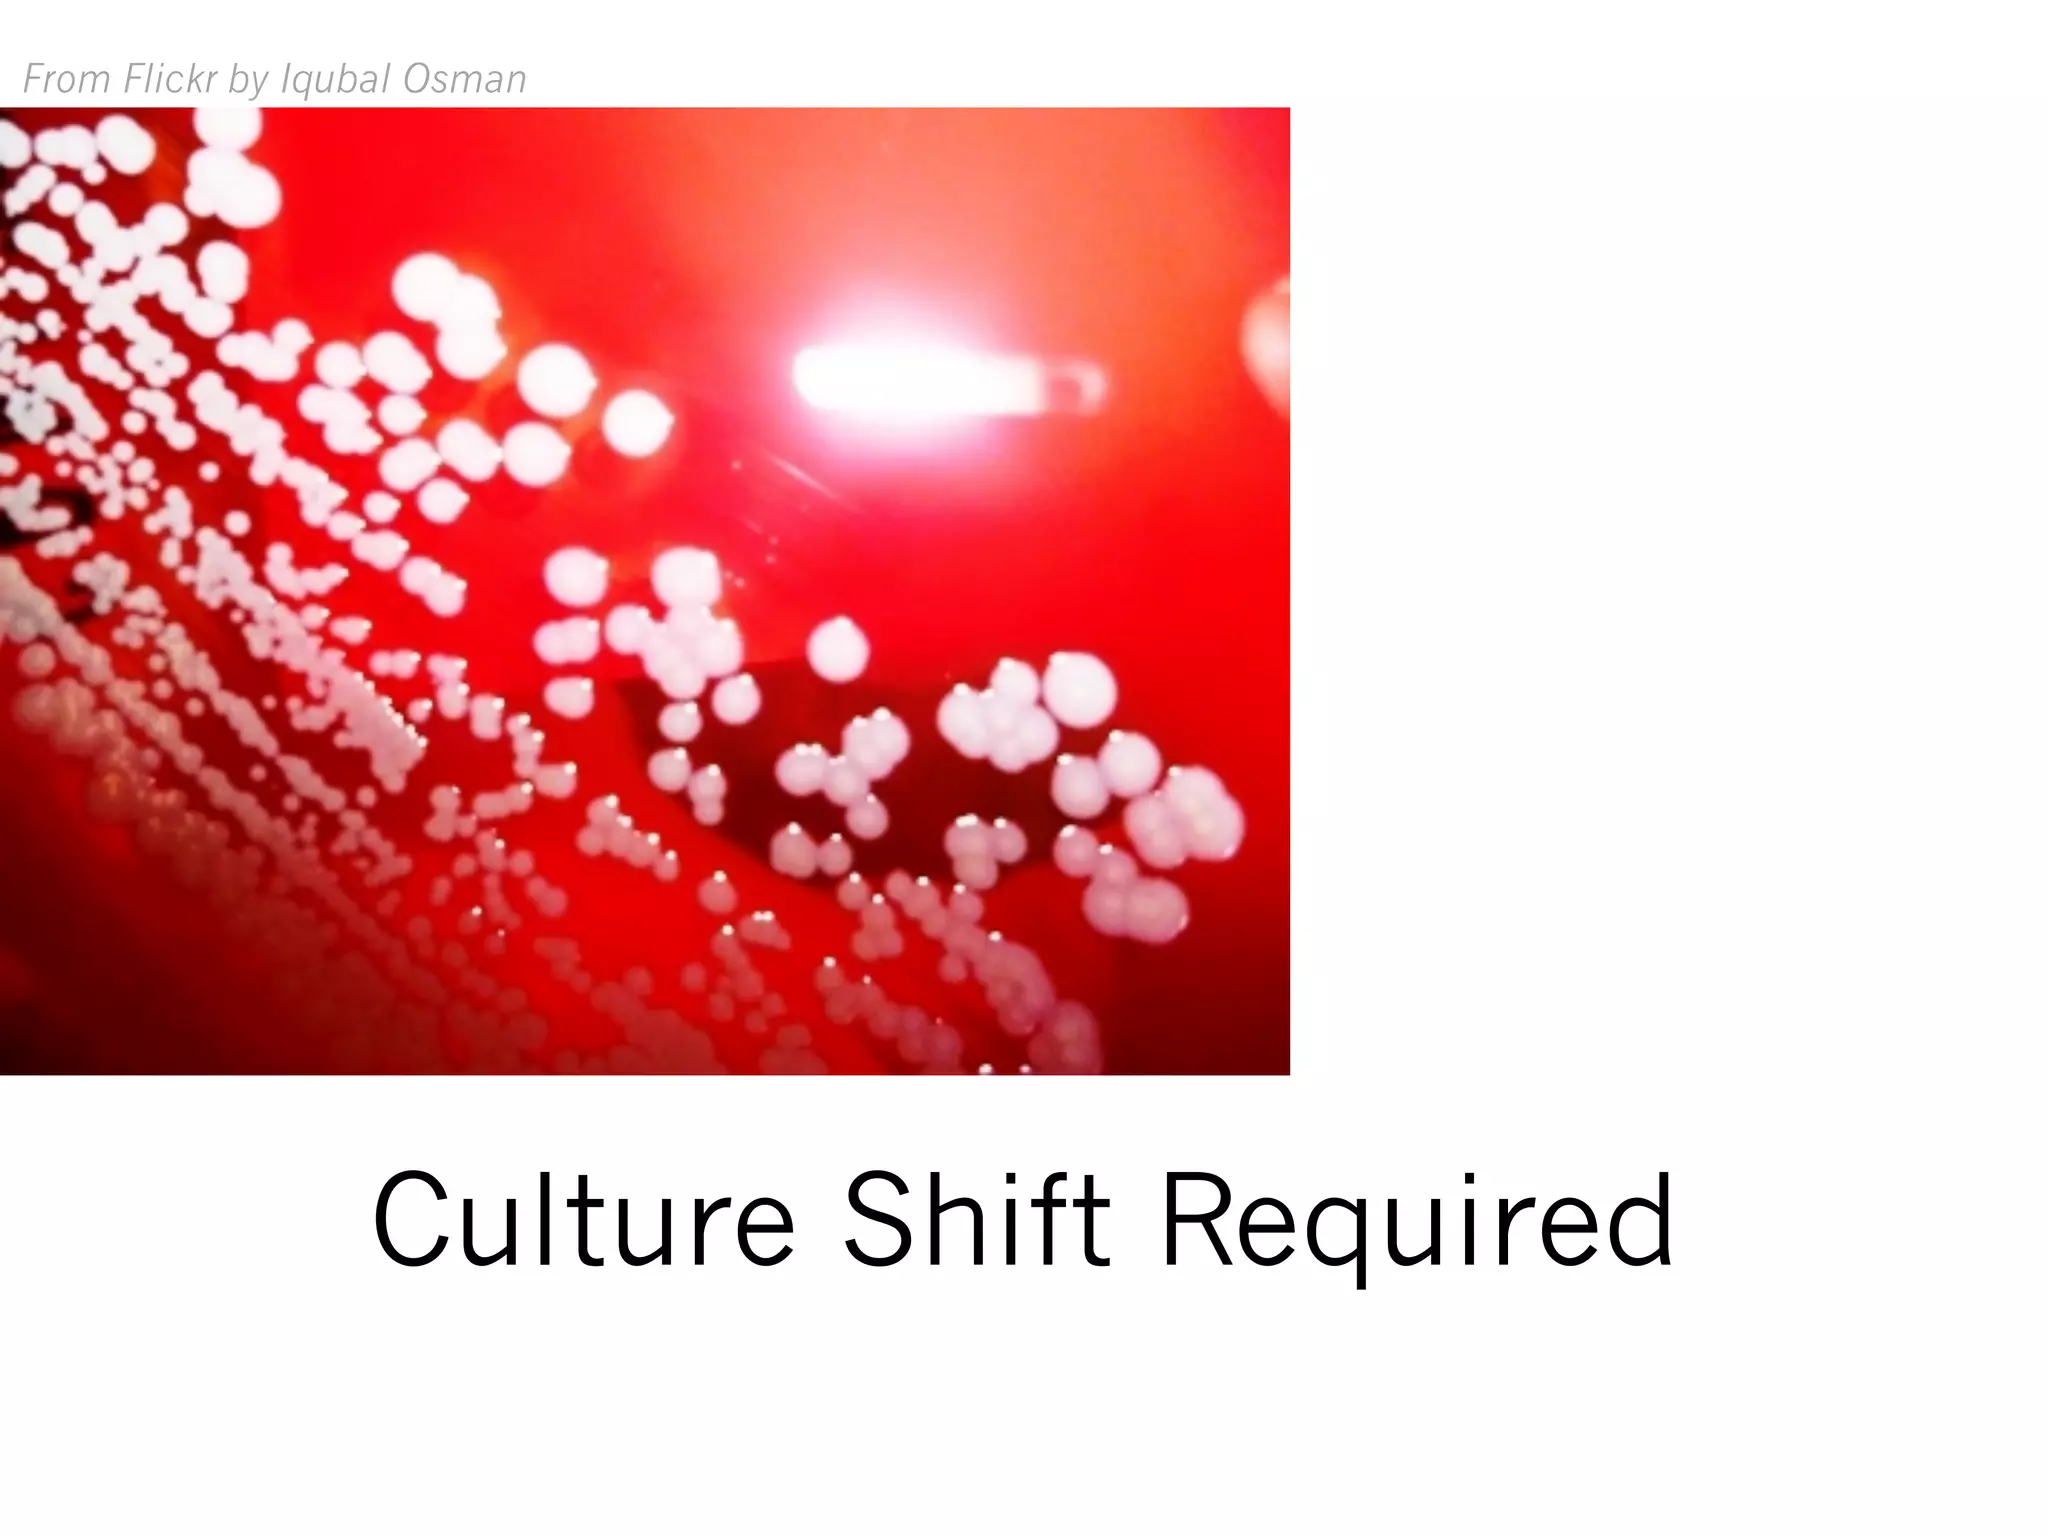
From Flickr by Iqubal Osman
Culture Shift Required

The document emphasizes the importance of open science, data sharing, and reproducibility in research to promote scientific integrity and progress. It discusses the need for researchers to work with libraries and publishers to change the culture of research and advocates for making data freely accessible. Additionally, it highlights various forms of open access, such as open access journals and repositories, and the benefits of open source software in collaborative research efforts.